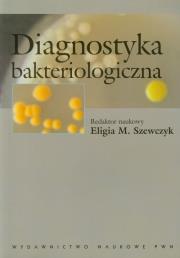
Opakowanie Diagnostyka bakteriologiczna

Diagnostyka bakteriologiczna
Wydawca:
Wydawnictwo Naukowe PWN
wysyłka: niedostępny
ISBN:
9788301144739
EAN:
978830114473905
Oprawa:
Miękka
Język:
polski
Format:
16.5x23.5cm
Liczba stron:
364
Rok wydania:
2010
(0) Sprawdź recenzje
19% rabatu
40,22 zł
Cena detaliczna:
49,90 zł
dodaj do schowka
koszty dostawy
Najniższa cena z ostatnich 30 dni: 40,22 zł
Opis produktuZasady bezpieczeństwa
Bakterie w organizmie człowieka – sprzymierzeńcy czy agresorzy?
W książce przedstawiono problemy diagnostyki bakteriologicznej uwzględniając 2 aspekty:
* szeroki przegląd bakterii związanych z człowiekiem
podstawy taksonomii bakterii, aktualna systematyka, dane dotyczące źródeł i rezerwuarów bakterii, najważniejsze cechy patogenezy i przebiegu zakażeń, rodzaje materiału klinicznego w diagnostyce chorób, szczegółowa charakterystyka tych cech ekologii, morfologii i metabolizmu bakterii, które mogą być wykorzystane w diagnostyce, a także tradycyjne i najnowsze metody identyfikacyjne (biologia molekularna);
* postępowanie diagnostyczne
przegląd materiałów klinicznych, sposoby ich pobierania, przechowywania i transportu, najkorzystniejsze metody identyfikacyjne i diagnostyczne, praktyczne schematy postępowania w badaniu materiałów klinicznych.
Książka przeznaczona dla studentów mikrobiologii, biotechnologii i ochrony środowiska, medycyny, pracowników laboratoriów mikrobiologicznych, stacji sanitarno-epidemiologicznych oraz lekarzy, zwłaszcza specjalizujących się w mikrobiologii.
Autorzy – nauczyciele akademiccy Uniwersytetu Medycznego w Łodzi – są doświadczonymi diagnostami laboratoryjnymi, specjalistami w dziedzinie mikrobiologii. Zespół tworzą: Eligia M. Szewczyk, Bożena Dudkiewicz, Paweł Lisiecki, Małgorzata Różalska, Maria Sobiś-Glinkowska, Jadwiga Szarapińska-Kwaszewska.
x

Uwaga!!!
Ten produkt jest zapowiedzią. Realizacja Twojego zamówienia ulegnie przez to wydłużeniu do czasu premiery tej pozycji. Czy chcesz dodać ten produkt do koszyka?
TAK
NIE

Wybierz wariant produktu
|





